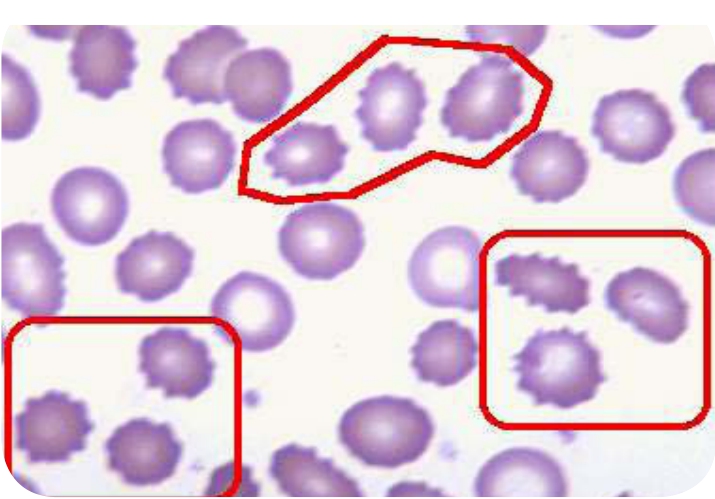
img67

生命的基因密码:遗传
-
1.1科学是一种世界观
-
1.2第一章 生命之谜——遗传概述
-
1.2.1第一节 神奇的生命——遗传
-
1.2.2第二节 生命之源——染色体
-
1.2.2.11.染色体和染色质的关系
-
1.2.2.22.染色体的变异
-
1.2.3第三节 遗传物质——基因
-
1.2.3.11.基因的产生
-
1.2.3.22.基因的特点
-
1.2.3.33.基因识别
-
1.2.3.44.基因工程
-
1.2.3.55.基因工程的应用领域
-
1.2.4第四节 奇异的精灵——变异
-
1.2.4.11.可遗传变异
-
1.2.4.22.生物突变
-
1.2.4.33.基因重组
-
1.2.4.44.变异在生物进化和农业生产中的意义
-
1.3第二章 生命密码——遗传进程
-
1.3.1第一节 物种起源
-
1.3.2第二节 生命起源
-
1.3.2.11.生命起源的创造论
-
1.3.2.22.生命起源的自然发生说
-
1.3.2.33.生命起源的化学说
-
1.3.3第三节 人类起源
-
1.4第三章 生命钥匙——遗传方式
-
1.4.1第一节 系谱及系谱分析
-
1.4.2第二节 遗传的基本定律
-
1.4.2.11.分离规律
-
1.4.2.22.独立分配规律
-
1.4.2.33.连锁遗传规律
-
1.4.3第三节 显性遗传与隐性遗传
-
1.4.3.11.常染色体显性遗传
-
1.4.3.22.常染色体显性遗传的传递方式
-
1.4.3.33.常染色体隐性遗传
-
1.4.3.44.常染色体隐性遗传的传递方式
-
1.4.4第四节 单基因遗传
-
1.4.5第五节 多基因遗传
-
1.4.6第六节 细胞质遗传
-
1.4.6.11.高等植物叶绿体的遗传
-
1.4.6.22.真菌类的线粒体遗传
-
1.4.7第七节 有性生殖
-
1.4.7.11.有性生殖的含义及起源
-
1.4.7.22.有性生殖的方式
-
1.4.8第八节 无性生殖
-
1.4.8.11.无性生殖的含义
-
1.4.8.22.无性生殖的方式
-
1.5第四章 人类成长的密码——发育与遗传
-
1.5.1第一节 人的体能与遗传因素
-
1.5.1.11.肌肉的耐力与遗传
-
1.5.1.22.肌肉的动作能力与遗传
-
1.5.1.33.平衡性与遗传
-
1.5.1.44.神经肌肉动作技巧与遗传
-
1.5.1.55.柔韧性与遗传
-
1.5.2第二节 生物的个体发育与遗传因素
-
1.5.2.11.被子植物的个体发育
-
1.5.2.22.高等动物的个体发育
-
1.5.2.33.高等动物个体发育过程(以蛙为例)
-
1.5.3第三节 胚前发育与遗传因素
-
1.5.3.11.胚前发育的类型
-
1.5.3.22.智商与遗传
-
1.6第五章 遗传中的奇妙
-
1.6.1第一节 双胞胎
-
1.6.2第二节 试管婴儿
-
1.6.3第三节 亲子鉴定
-
1.7第六章 难以想象——遗传疾病
-
1.7.1第一节 遗传疾病的概述
-
1.7.2第二节 遗传疾病的分类
-
1.7.2.11.单基因遗传病
-
1.7.2.22.常染色体隐性遗传
-
1.7.2.33.X连锁显性遗传病
-
1.7.2.44.X连锁隐性遗传病
-
1.7.2.55.多基因遗传病
-
1.7.2.66.先天性疾病是遗传病吗
-
1.7.3第三节 遗传病治疗与防治
-
1.7.3.11.避免近亲结婚
-
1.7.3.22.开展遗传咨询
-
1.7.3.33.避免接触致变剂
-
1.7.3.44.提倡婚前检查与适龄生育
-
1.7.3.55.基因疗法